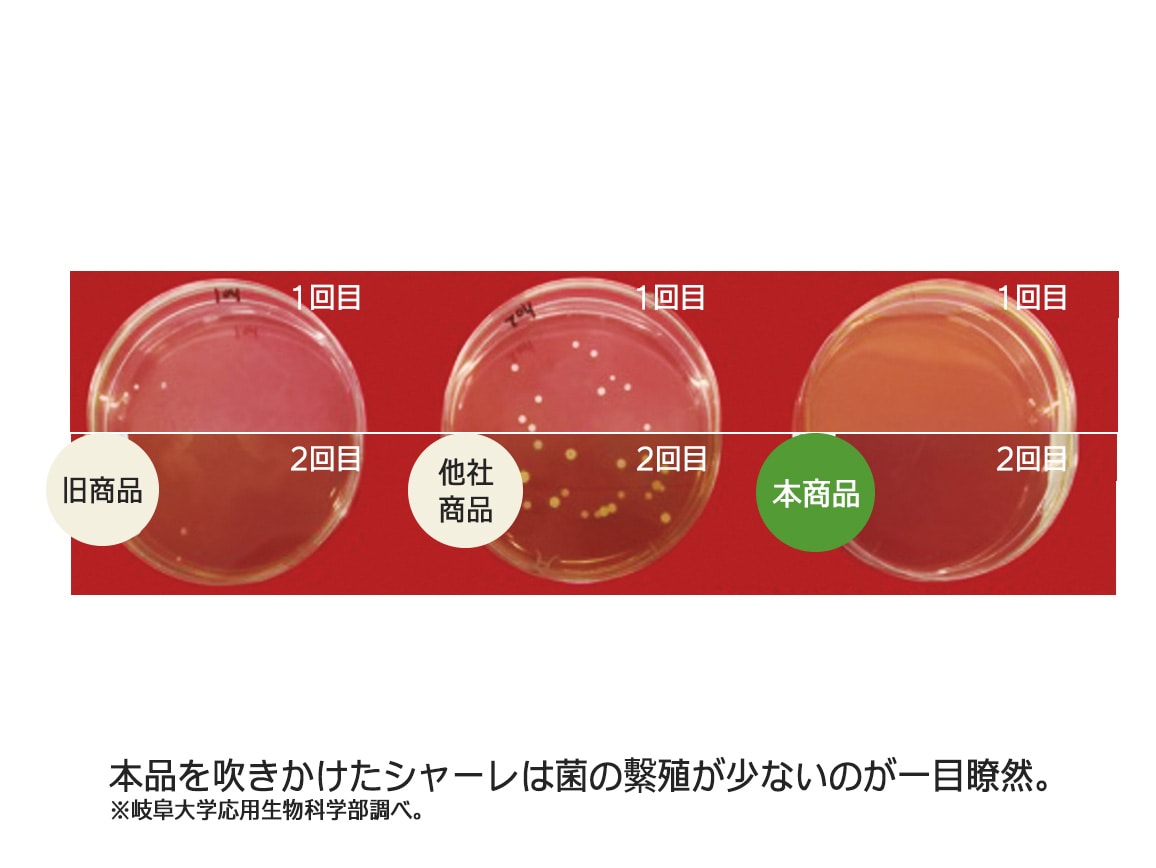
サニーシールドAg+ スプレー サニーシールドAg+ スプレー

- ハルメクTOP
- 生活雑貨
- 掃除・洗濯用品・トイレグッズ
- サニーシールドAg+ スプレー
無香料
サボン





商品説明
サニーシールドAg+ スプレー
2,420 円 (税込)
24 ポイント 還元
■おトクなセットを販売中!
「サニーシールドAg+ スプレー+詰め替えセット」を見る
- 在庫あり
- 残りわずか
- お待たせ
- 売り切れ(入荷お知らせメールを受け取る)
日付はお届け予定日です。
無香料
サボン
数量
- 都合により入荷しない場合がございます。ご了承ください。
-
こちらは予約注文ではありません。
入荷お知らせメールについて詳しくはこちら - 入荷お知らせ一覧はこちら
- 都合により入荷しない場合がございます。ご了承ください。
-
こちらは予約注文ではありません。
入荷お知らせメールについて詳しくはこちら - 入荷お知らせ一覧はこちら
ご希望の色・サイズを選択すると
入荷お知らせメールを申込めます。
お届け日の目安
04月11日頃
地域・商品によっては、もう少し日数をいただく場合があります。
仕様
■セット内容/キャップ付きトリガーボトル1本、トリガー1本●内容量(約)/300ml
●成分/四級アンモニウム塩、化粧品添加用オイル、銀イオン
●液性/中性
備考
※日本製※容器を入れ替えたり、他の製品との併用は避け、必ず単独で使用してください。
※革製品など水洗い不可表示のあるもの、染加工などの特殊加工されたものはシミや変色の恐れがあるので予め目立たない部位でお試しください。
※全ての菌を除去するわけではありません。
※のし包装は承れません。

汚れだけじゃなくニオイまでこれでひと拭きすればOK!
こちらはスプレーのみです。
毎日の掃除っておっくうだし大変。でもこの洗剤なら、汚れもニオイも落とせて、コーティングで次の汚れまでつきにくくなるから、掃除の回数を減らせてラクできる。水まわり、床、テーブル、窓から家電にカーテンまで、家中これ一本。他の洗剤を買う必要がないから、経済的。掃除の場所によって洗剤を替える必要がないから掃除の手間もなくなる!
■1本7役で、家中のきれいが長続き。水まわり、床、トイレ、カーテン、ソファまで!
汚れ落とし、消臭、コーティング、防カビ、除菌、ツヤ出し、花粉落とし
\ハルメク編集部で試してみました。/
・キッチンシンクや水切り台の汚れと水あか。いつもの洗剤では落ちなかったのに、きれいになりました!(田村史乃)
・浴室の排水口の汚れもヌメリもするんと落とせて、イヤなニオイまでなくなりました。掃除の回数が減らせるのもうれしい!(金田由紀子)
・掃除がしづらい家電やカーテンに。テレビはホコリがつきにくくなりカーテンのニオイも花粉も気にならなくなりました。(宮沢淳)